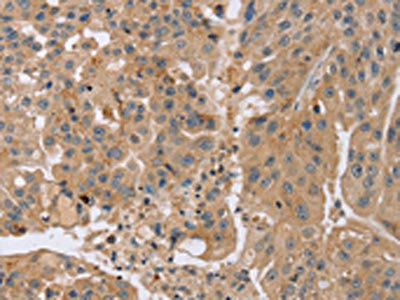

KCNJ15 Antibody
-
中文名稱:KCNJ15兔多克隆抗體
-
貨號:CSB-PA999839
-
規格:¥1100
-
圖片:
-
The image on the left is immunohistochemistry of paraffin-embedded Human breast cancer tissue using CSB-PA999839(KCNJ15 Antibody) at dilution 1/35, on the right is treated with synthetic peptide. (Original magnification: ×200)
-
The image on the left is immunohistochemistry of paraffin-embedded Human tonsil tissue using CSB-PA999839(KCNJ15 Antibody) at dilution 1/35, on the right is treated with synthetic peptide. (Original magnification: ×200)
-
Gel: 8%SDS-PAGE, Lysate: 40 μg, Lane: Mouse pancreas tissue, Primary antibody: CSB-PA999839(KCNJ15 Antibody) at dilution 1/200, Secondary antibody: Goat anti rabbit IgG at 1/8000 dilution, Exposure time: 30 seconds
-
-
其他:
產品詳情
-
Uniprot No.:
-
基因名:KCNJ15
-
別名:KCNJ15; KCNJ14; ATP-sensitive inward rectifier potassium channel 15; Inward rectifier K(+ channel Kir1.3; Inward rectifier K(+ channel Kir4.2; Potassium channel, inwardly rectifying subfamily J member 15
-
宿主:Rabbit
-
反應種屬:Human,Mouse,Rat
-
免疫原:Synthetic peptide of Human KCNJ15
-
免疫原種屬:Homo sapiens (Human)
-
標記方式:Non-conjugated
-
抗體亞型:IgG
-
純化方式:Antigen affinity purification
-
濃度:It differs from different batches. Please contact us to confirm it.
-
保存緩沖液:-20°C, pH7.4 PBS, 0.05% NaN3, 40% Glycerol
-
產品提供形式:Liquid
-
應用范圍:ELISA,WB,IHC
-
推薦稀釋比:
Application Recommended Dilution ELISA 1:2000-1:5000 WB 1:500-1:2000 IHC 1:25-1:100 -
Protocols:
-
儲存條件:Upon receipt, store at -20°C or -80°C. Avoid repeated freeze.
-
貨期:Basically, we can dispatch the products out in 1-3 working days after receiving your orders. Delivery time maybe differs from different purchasing way or location, please kindly consult your local distributors for specific delivery time.
-
用途:For Research Use Only. Not for use in diagnostic or therapeutic procedures.
相關產品
靶點詳情
-
功能:Inward rectifier potassium channels are characterized by a greater tendency to allow potassium to flow into the cell rather than out of it. Their voltage dependence is regulated by the concentration of extracellular potassium; as external potassium is raised, the voltage range of the channel opening shifts to more positive voltages. The inward rectification is mainly due to the blockage of outward current by internal magnesium.
-
基因功能參考文獻:
- KCNJ15 couples with polyamines in sensing weak electric fields. PMID: 26449415
- RNA-seq evidence of biallelic expression of KCNJ15 and 10 neighboring genes in at least one primary human tissue tested indicates that the expression of KCNJ15 is uncoupled from the control of the maternally inherited 5mCpG imprints at the WRB differentially methylated region (DMR) in disomic controls or trisomy (Down syndrome) individuals. PMID: 27100087
- KCNJ15 has a major role in histamine-stimulated gastric acid secretion. PMID: 26108660
- We had performed a replication study using an independent larger Japanese population for the association of rs3746876 within KCNJ15, and observed a significant association of rs3746876 with type 2 diabetes, but this study failed to find original finding. PMID: 23595124
- It was shown that downregulation of Kcnj15 leads to increased insulin secretion in vitro and in vivo. The mechanism for regulating insulin secretion inolved a calcium-sensiong receptor. PMID: 22566534
- KCNJ15 is a previously unreported susceptibility gene for T2DM among Asians PMID: 20085713
- maintaining electrical integrity of bile-generating hepatocytes. PMID: 11804844
- The potential synergy and consequences of the overexpression of KIR4.2 and KIR3.2 in Down's syndrome brain development are discussed. PMID: 15068243
- MUPP1 and Kir4.2 may participate in a protein complex in the nephron that could regulate transport of K(+) as well as other ions. PMID: 19420109
顯示更多
收起更多
-
亞細胞定位:Membrane; Multi-pass membrane protein.
-
蛋白家族:Inward rectifier-type potassium channel (TC 1.A.2.1) family, KCNJ15 subfamily
-
數據庫鏈接:
Most popular with customers
-
-
YWHAB Recombinant Monoclonal Antibody
Applications: ELISA, WB, IHC, IF, FC
Species Reactivity: Human, Mouse, Rat
-
Phospho-YAP1 (S127) Recombinant Monoclonal Antibody
Applications: ELISA, WB, IHC
Species Reactivity: Human
-
-
-
-
-